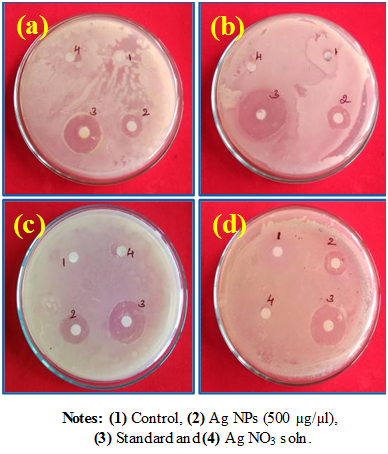

International Journal of
eISSN: 2573-2838


Research Article Volume 5 Issue 4
1Department of Chemistry, Shridevi Institute of Engineering and Technology, India
2Department of Chemistry, Siddaganga Institute of Technology, India
3Department of Biotechnology, Shridevi Institute of Engineering and Technology, India
Correspondence: Chandrasekhar N, Research and Development Center, Department of Chemistry, Shridevi Institute of Engineering and Technology, Tumakuru - 572106, India
Received: May 24, 2019 | Published: July 11, 2019
Citation: Vinay SP, Chandrasekhar N, Udayabhanu. Ixora coccinea extract-mediated green synthesis of silver nanoparticles: Photodegradative and antimicrobial studies. Int J Biosen Bioelectron. 2019;5(4):100?105. DOI: 10.15406/ijbsbe.2019.05.00161
Silver nanoparticles (Ag NPs) was synthesized by green synthesis method using Ixora coccinea leaves extract as fuel. The structure and morphology of the product were characterized by Powder X-ray Diffraction, UV–Visible spectroscopy, Scanning Electron Microscopy and Transmission Electron Microscopy. The nanoparticles (NPs) were subjected to photocatalytic and antimicrobial studies. PXRD pattern demonstrates that the formed product belongs to the cubic crystal system. SEM images show that the particles are agglomerated to form spherical like structure and the average crystallite sizes were found to be 20nm. The prepared Ag NPs exhibit excellent photocatalytic activity for the photodegradation of methylene blue (MB) indicating that the Ag NPs are potential photocatalytic semiconductor materials. Ag NPs exhibit significant bactericidal activity against gram-positive (Pseudomonas aeruginosa, Escherichia coli and Klebsiella aerogenes) and gram-negative (Staphylococcus aureus) bacteria using the disc diffusion method. The study successfully demonstrates the synthesis of Ag NPs by simple eco-friendly route employing Ixora coccinea as a fuel that exhibits superior Photodegradative and antibacterial activities.
Keywords: green synthesis, Ixora coccinea, photocatalyst, dye degradation, antibacterial
In recent years, nanomaterials have been broadly studied compared to their huge materials due to their interesting physio-chemical properties.1 Presently, the photocatalytic degradation has much alarming technique green-assisted technology for making free from organic and inorganic toxic pollutants in wastewater. Semiconductor Photocatalysis is a favorable technique with various advantages such as air and water purification, water disinfection, and hazardous waste remediation in the environment. Ag NPs assisted photocatalytic degradation is an ideal and excellent technique for degradation of organic pollutants and dye in wastewater.Figure 1 The organics are entirely mineralized into the water, carbon dioxide, and corresponding mineral acids without creating any hazardous by-products. This technique has been used for the pronominalization of carcinogenic dyes (Methylene blue (MB) and azo dyes etc.,).2,3 Among NPs, Ag NPs have patent applications in the area of life-sciences particularly in forensic science, food chemistry, cosmetics and agriculture.4–7 The reputation and diversity of these applications have produced a great deal of notice in developing multipurpose methods to synthesize Ag NPs with controlled and precise properties. Numerous approaches used to date include a reduction in chemical, photochemical and solutions reaction in thermal decomposition and reverse micelles of Ag compounds, electrochemical, biosynthesis, radiation-assisted and recently, bio-synthesis using living-plant systems.8–21 The present work reports the synthesis of Ag NPs via green route using Ixora coccinea as fuel. The prepared Ag NPs were characterized using powder X-ray diffraction (PXRD), UV-Visible spectrum (UV-Vis), scanning electron microscopy (SEM) and transmission electron microscopy (TEM) of the Ag NPs.
All chemicals utilized were of analytical grade. AgNO3 (Silver nitrate) was purchased from Merck. MB dye was bought from S.D fine chemicals limited then utilized without further purification. Ixora coccinea leaves were collected from the college of S.I.E.T, College campus.
Collection and preparation of leaves extract
The leaves of Ixora coccinea plant leaves were collected and washed with tap water to remove the dirt on the leaves. Then the leaves were rinsed with distilled water and subjected for shade drying. Then 20g of leaves were chopped into small pieces by scissors. These chopped leaves were heated on 100mL of water at 60oC for 20minutes. During the course of heating, all the water-soluble phytochemicals were extracted to water, and then we have filtered the mixture and taken the water extract. The water extract (10mL) was subjected to drying on Petri plates in a hot air oven and got the final weight of 60mg/10mL. The gotten product (60mg) was used for the synthesis of Ag NPs (Figure 2).22
Characterization techniques
Synthesized silver nanoparticles were characterized by Agilent Technologies-Cary 60 UV-Vis spectrophotometer. X-ray diffraction (Rigaku Smart Lab) measurement was used to study the phase and purity of the sample. Morphological distribution of the Nanoparticles was studied using TEM (Jeol/JEM 2100) and SEM (JEOL Model JSM- 6390LV) analysis. Heber-Scientific Photo reactor was using to study about Photocatalytic activity.
Photocatalytic activity
Prepared Ag NPs were taken for degradation of methylene blue (MB) using 300W visible light as radiance source. 50 mg of the photocatalyst was added to 100mL of MB solution (5ppm) in a HEBER photo reactor. The solution was continuously mixed bypassing air in dark for 30minutes to confirm adsorption-desorption equilibrium between MB and photocatalyst before irradiation.23 The suspension was taken from the solution mixture at intervals of 30minutes. The dispersed Ag NPs photocatalyst was removed using a spin win micro centrifuge. The degradation % can be calculated using the formula.
% of degradation = (Ci - Cf)/ Ci×100 ………… (i)
Where Ci and Cf are the initial and final concentration of the dye.
Synthesis of Silver Nanoparticles using leaves extract
The aqueous AgNO3 solution (5mM) were equipped and used for the Ag NPs synthesis. The synthesis of silver nanoparticles was carried out at ambient temperature for twenty-four hours and kept it in dark condition to prevent agglomeration. 10mL of Ixora coccinea leaves extract was added to the AgNO3 (90mL) solution and located on a magnetic stirrer for ten minutes. After 24h to get complete bio reduced Ag ions. The obtained silver nanoparticles were cleaned by frequent centrifugation at 8,000rpm for fifteen minutes.24 Additionally, the final material was dried and kept for additional inspection (Figure 3).
Figure 4 shows the XRD pattern, which is the primary tool for the characterization of silver nanoparticles. The diffraction peaks at 2θ=38.06°, 44.18°, 64.23°, and 77.54° were indexed with the planes (111), (200), (220) and (311) for the resultant particles with cubic phase. The structure of obtained data well matches with the JCPDS card no. 1-1167. Plotted XRD pattern indicates the formation high purity of the silver nanoparticles and there are no contamination peaks were detected. This calculation exposes that the average crystallite size (D) of Ag nano powder was found to be 13.04nm using Debye Scherrer’s equation.25
UV-Vis spectroscopy
Figure 5A shows the ambient temperature UV–vis spectrum of the silver NPs. The maximum absorbance was obtained at 425nm (confirming the formation of silver nanoparticles) due to surface plasmon absorption.26 A Figure 5B show the obtained band gap value was 2.75eV; this value has been confirmed by indirect calculation from the absorption spectra using Tauc’s equation. The calculated band gap of silver nanoparticles is useful for the photocatalytic activity.
Scanning electron microscopy
SEM images of Ag NPs are shown in Figure 6A & 6B. From the SEM images, it is clearly confirmed that the material synthesized by greenway is almost uniform spherical in nature. The particles are agglomerated crystals and look like a spherical like structures.27
Transmission electron microscopy
Figure 7A shows the TEM image of Ag NPs, which are almost spherical in shape with an average particle size of 20nm (Figure 7B).
Photocatalytic dye degradation
Mechanism: A schematic representation of the degradation of MB using Ag NPs is shown below:
Ag + hν → Ag (h+vb + e-cb)
OH−ads + h+vb → OH•ads (in basic medium)
MB + OH•ads →dye degradation
MB is a carcinogenic dye, the Photocatalysis of MB dye was carried using synthesized silver nanoparticles at varying time intervals in the visible region. Figure 8A shows that the rate of the absorption band of MB from UV-vis spectrophotometer at 664nm. So, it is observed that the 5ppm/100mL of MB undergo 87% in a period of 3h as shown in Figure 8B.
Antibacterial assay
Cell membrane with negative charge and silver with a positive charge mutually attract. Supplementary, silver ions enter into the cell membrane and react with the thiol groups present on the cell membrane and destruction it leading to the death of the cells. Considering the above facts, the probable schematic diagram is shown in Figure 9.28,29 The significant antibacterial properties of silver nanoparticles were assessed by taking Gram-negative Pseudomonas aeruginosa, Klebsiella aerogenes and E-coli and Gram-positive Staphylococcus aureus bacteria’s using disc-diffusion technique.30–33 In the disc-diffusion technique, the silver NPs shows significant antibacterial activity for all (Figure 10). The measured zone of inhibition was revealed in Table 1.
Figure 10 Antibacterial activity of green synthesis of Ag nanoparticles against pathogenic bacterial strains such as (A) Klebsiella aerogenes, (B) Staphylococcus aureus, (C) Pseudomonas aeruginosa and (D) Escherichia coli.
S. No. |
Treatment |
Klebsiella aerogenes |
Staphylococcus aureus |
Pseudomonas |
Escherichia |
1 |
Control |
NA |
NA |
NA |
NA |
2 |
Ag NPs (500 µg/µL) |
4.63 ± 0.19 |
5.50 ± 0.29 |
5.10 ± 0.21 |
4.00 ± 0.29 |
3 |
Standard |
7.00 ± 0.29 |
10.83 ± 0.33 |
7.50 ± 0.29 |
7.63 ± 0.19 |
4 |
Plant extract |
NA |
NA |
NA |
NA |
Table 1 Antibacterial activity of Ag NPs on pathogenic bacterial strains Values are the mean ± SE of inhibition zone in mm. NA Symbols represent no antibacterial activity was found in this work.
From this study, the Ag NPs was successfully synthesized by green reduction method using a very common garden plant Ixora coccinea as a fuel. The Ag NPs are confirmed by PXRD and FT-IR studies. The SEM and TEM analysis showed spherical shape structure with 20nm particle size. The dye degradation and antibacterial action of the prepared Ag NPs were found to be noteworthy. The technique is a very inexpensive and greener approach which produces Ag nanoparticles having a variety of applications. Consequently, this technique may be utilized for huge scale production of Ag nanoparticles.
Dr. Chandrasekhar and Vinay thank Dr. M R Hulinaykar, Managing Trustee, Sri Shridevi Charitable Trust, and Shridevi Institute of Engineering and Technology for encouragement and support for research work. The authors also thank Siddaganga Institute of Technology for providing the lab facilities. Dr. GN Thanks DST Nanomission (SR/NM/NS-1262/2013) for financial support.
Author declares that there is no conflict of interest.

©2019 Vinay, et al. This is an open access article distributed under the terms of the, which permits unrestricted use, distribution, and build upon your work non-commercially.